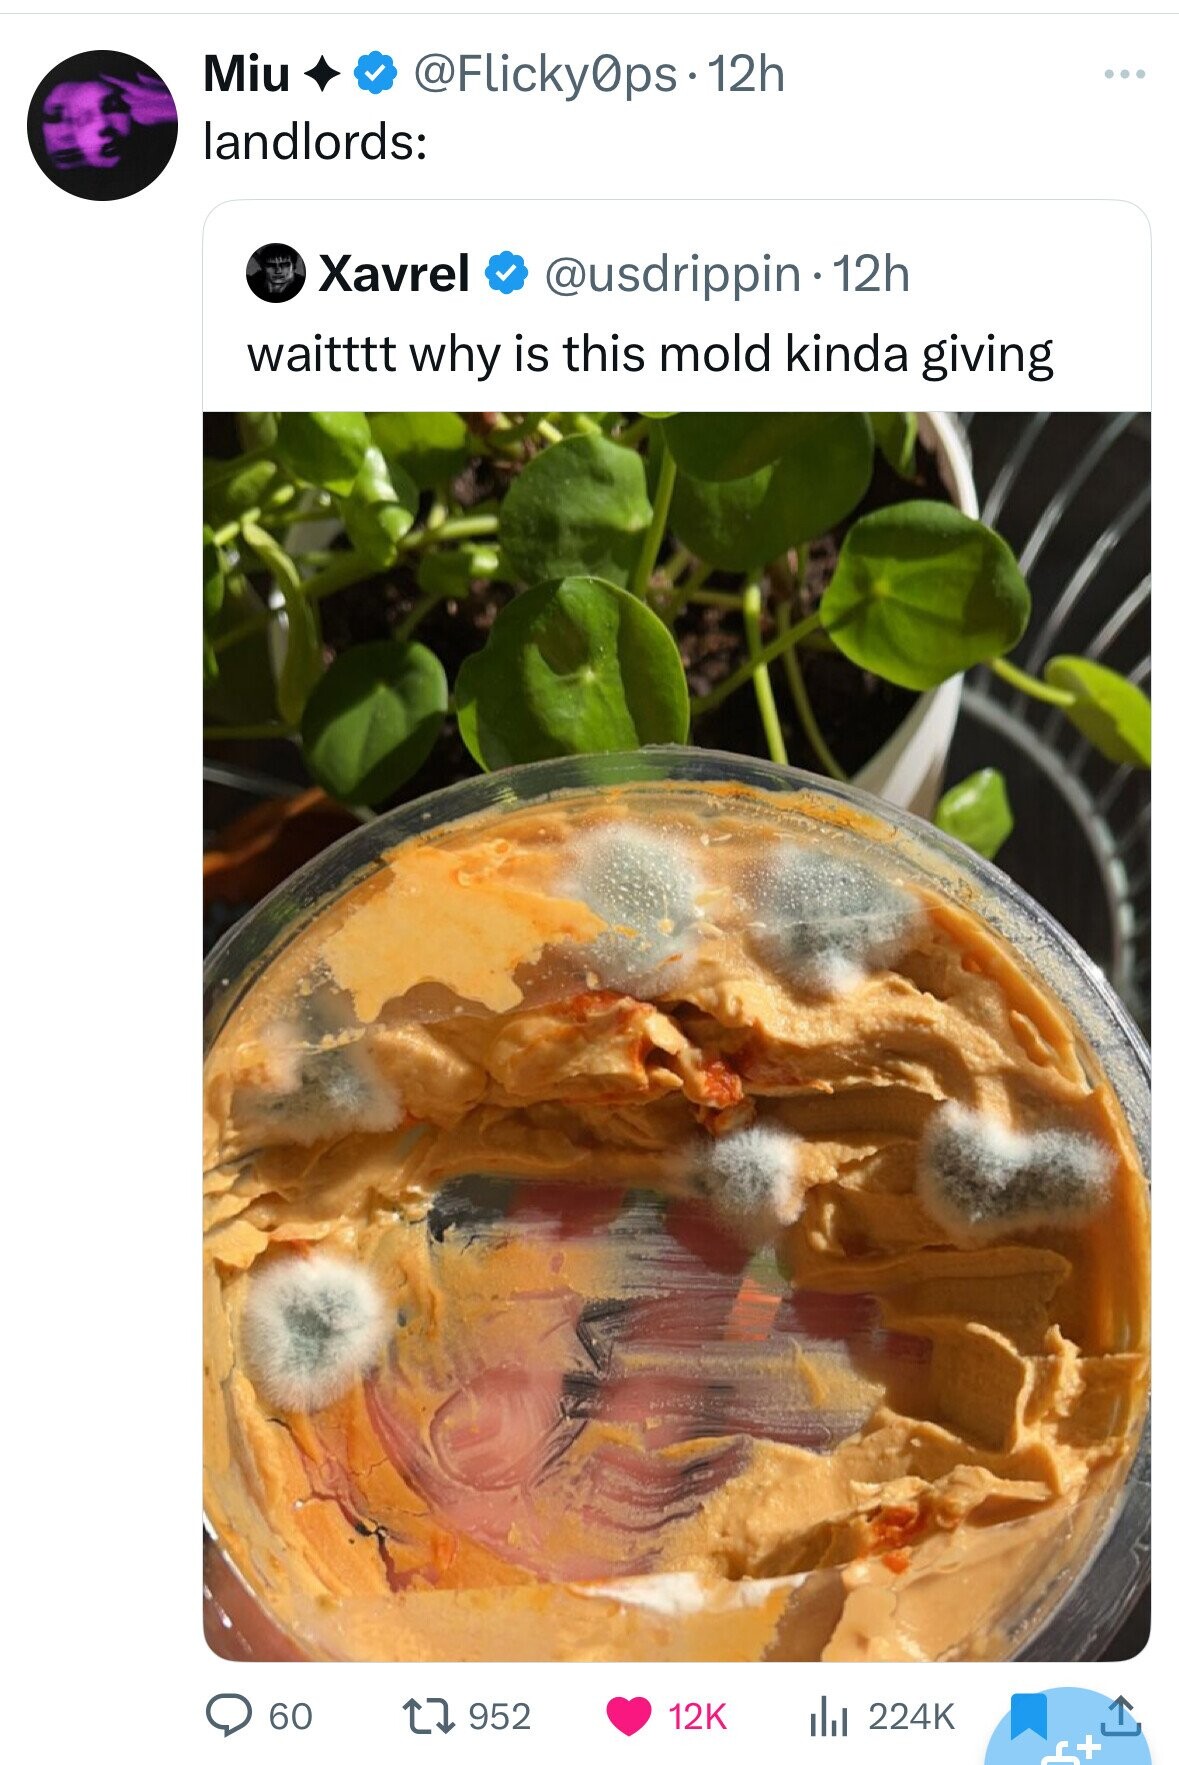
Miu @Flicky0ps.12h landlords: Xavrel @usdrippin 12h waitttt why is this mold kinda giving 60 952 12K 224K +ء

54 of the Funniest Burns from the Week of September 8, 2025
Earlier this week, Apple revealed they couldn’t resist hopping on the Ozempic trend, and unveiled the first-ever iPhone Air during an event at their California headquarters. Touted as “the thinnest iPhone ever” at just 5.6 millimeters thick, Apple argued that the phone, which starts at an eye-watering $999, was its most durable yet.
“It’s a paradox you have to hold to believe,” industrial designer Abidur Chowdhury said during the Tuesday presentation.
But not everyone was on board with the tiny iPhone. Beyond questioning the iPhone Air’s massive camera and wondering just how long it’ll take for all of our iPhones to “mysteriously” slow down, some had concerns about the product's alleged durability. Namely, wasn’t that the same thing Apple said about the notoriously bendy iPhone 6?
“iPhone Air 10 minutes out of the box,” one Twitter user captioned a photo of an apparent “bendgate” victim, while another joked about the massive OtterBox inevitably required to protect the ultra-thin electronic.
That said, Apple’s latest offering wasn’t the only thing that got roasted this week. Other digital burns scorched the Los Angeles Chargers, questionable FanDuel graphics and Rudy Giuliani’s spray tan.